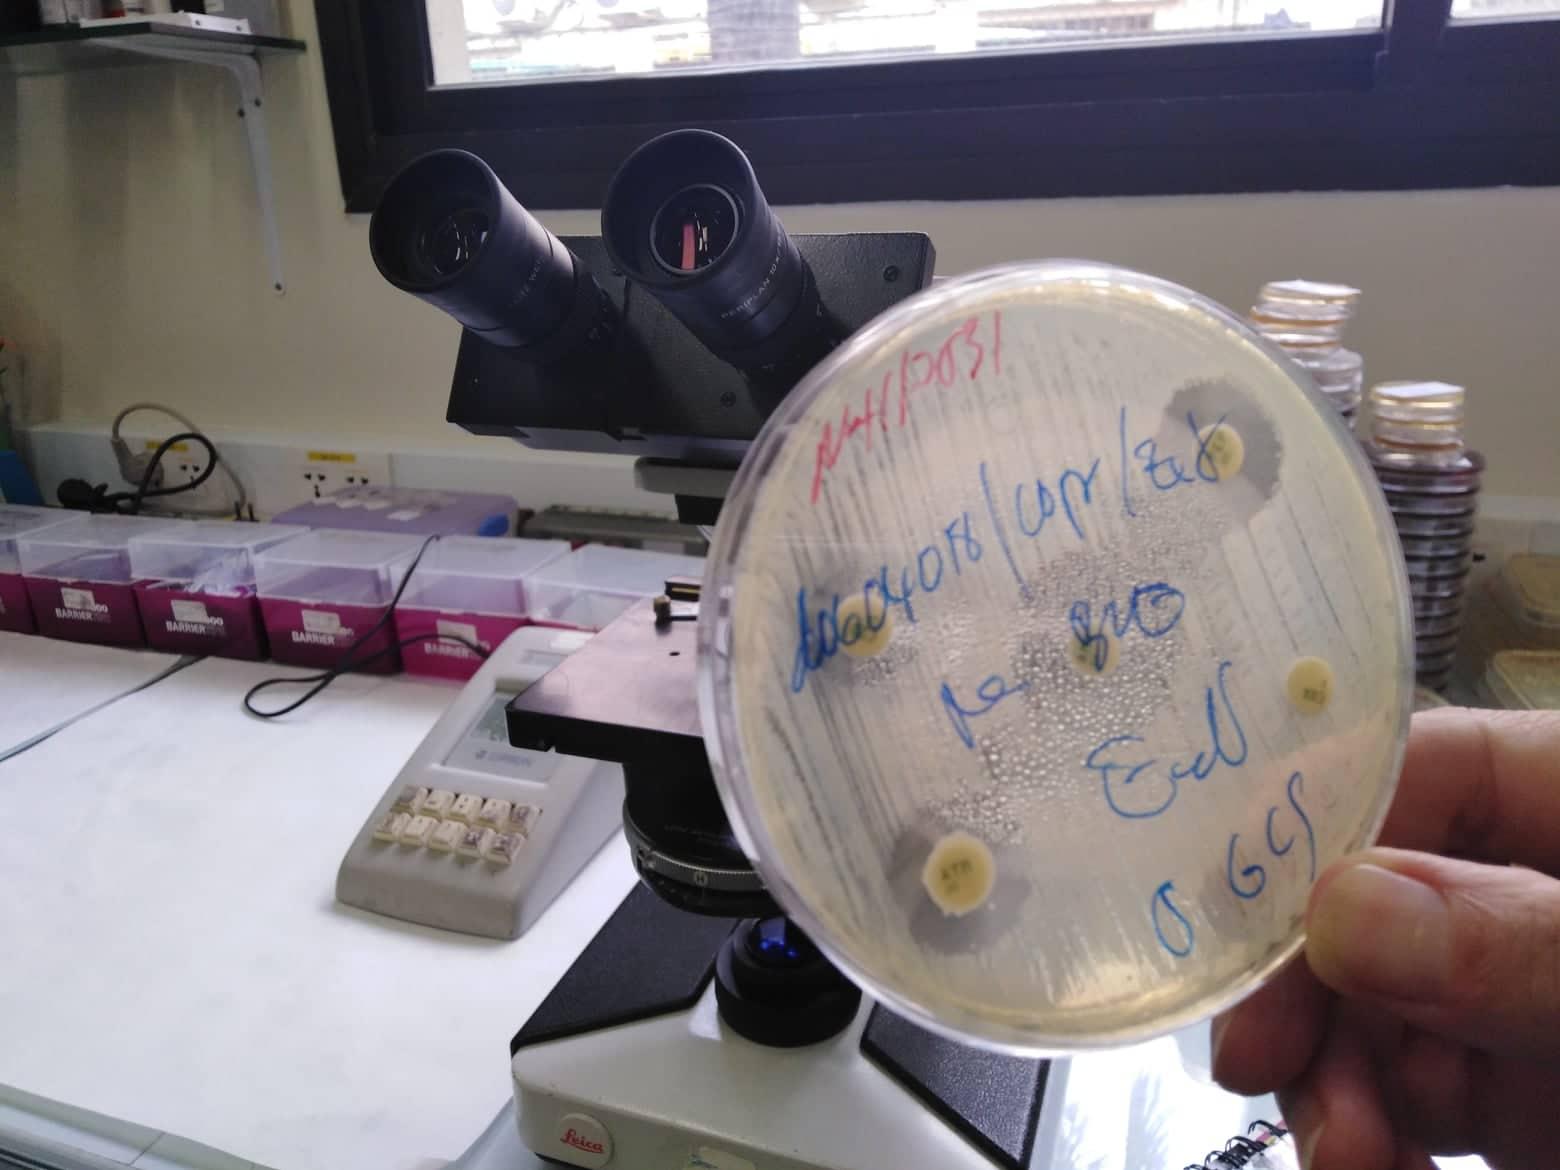
antibiotiques institut pasteur cambodge

Les bactéries ont développé de fortes résistances au Cambodge selon l’Institut Pasteur. Un phénomène qui s’explique par un mauvais usage des antibiotiques, ce qui peut mener à une impasse thérapeutique.
Elles constituent une grave menace sur la santé mondiale. Pour ne pas être éliminées, elles évoluent. Les bactéries auront toujours une longueur d’avance face aux antibiotiques. La course aux armements dure depuis l’invention de la pénicilline en 1928. « Toutefois, si l’humain ne peut pas gagner la guerre contre les bactéries, les dégâts peuvent être limités grâce à de meilleurs diagnostics, prescriptions de médicaments et mesures de contrôle », déclare Didier Fontenille, le directeur de l’Institut Pasteur du Cambodge. Certaines bactéries présentent des résistances naturelles qui sont connues, mais un mauvais usage des antibiotiques participe à l'acquisition de résistances à d'autres antibiotiques auxquels les bactéries sont généralement sensibles.
L'utilisation inappropriée de médicaments est courante au Cambodge et a contribué à l'émergence d'une résistance chez de nombreuses espèces de bactéries. « La plus grande résistance au Cambodge concerne la fluoroquinolone, un antibiotique très fréquemment utilisé. Il n’y plus une seule salmonelle responsable de fièvre typhoïde qui ne soit pas résistante au fluoroquinolone », révèle Alexandra Kerléguer, chef de l’unité de biologie médicale de l’Institut Pasteur du Cambodge.
L’Institut Pasteur a donc décidé de mettre en place une surveillance des résistances des entérobactéries analysées dans son laboratoire. Plus de 10 000 échantillons ont été analysés entre 2012 et 2015. Les biologistes ont alors pu observer que la proportion d'entérobactéries produisant des bêta-lactamases à large spectre - en d’autres termes, le nombre de bactéries résistantes aux bêta-lactamines, comprenant les pénicillines et les céphalosporines, qui sont aussi fréquemment résistantes à d’autres antibiotiques - a augmenté, passant de 23,8 % à 38,4 %, pendant la période de l'étude. D’après Alexandra Kerléguer, co-auteure de cet article scientifique analysant l’évolution des entérobactéries, les causes de cette évolution sont multiples. « La principale cause est la prescription, distribution et utilisation abusives d’antibiotiques à large spectre. Les médicaments sont en vente libre au Cambodge, il n’est pas nécessaire de présenter une ordonnance. La durée de traitement n’est souvent pas respectée et en plus, certains antibiotiques contrefaits ne sont pas assez dosés. En plus d’être inefficaces, cela va renforcer la résistance des bactéries », développe-t-elle.
L’utilisation non raisonnée d’antibiotiques pendant le traitement des infections n’est pas le seul facteur de résistance. L’emploi des antibiotiques chez les animaux contribue aussi à augmenter la résistance des bactéries.
Ces bactéries pathogènes résistantes peuvent se transmettre facilement entre individus, tout comme n’importe quelle bactérie. Le transfert de germes peut avoir lieu en buvant à la même bouteille ou par contact indirect puisque les bactéries peuvent survivre sans hôte sur une longue période. Des résistances aux antibiotiques apparaissent fréquemment en milieu hospitalier. « Les hôpitaux cambodgiens sont très lacunaires en ce qui concerne la mise en place de mesures d’hygiènes. Le contrôle des infections dans les établissements sanitaires n’est pas assez important, même s’il y a des progrès », indique la biologiste. En effet, le nombre d’échantillons porteurs de bactéries résistantes (BLSE) analysés par l’Institut Pasteur a diminué de 2,5% entre 2015 et 2018. « Même si la diminution du pourcentage de BLSE sur les 2 périodes ne semble pas significative, cette baisse est certainement due à une prise de conscience des prescripteurs », avance Alexandra Kerleguer.
Au Cambodge, la tendance à prendre du retard sur cette course aux armements peut être contrée par des mesures à tous les niveaux de la société. A l’échelle individuelle, il est important de suivre les règles d’hygiène de base et d’utiliser des antibiotiques uniquement lorsqu’ils sont prescrit par un professionnel de santé qualifié. « Si quelqu’un considère qu’il a besoin d’antibiotiques, il faut d’abord qu’il aille consulter, conseille la biologiste française. Il est irresponsable de prendre des antibiotiques de sa propre initiative ».
Sur le même sujet

















